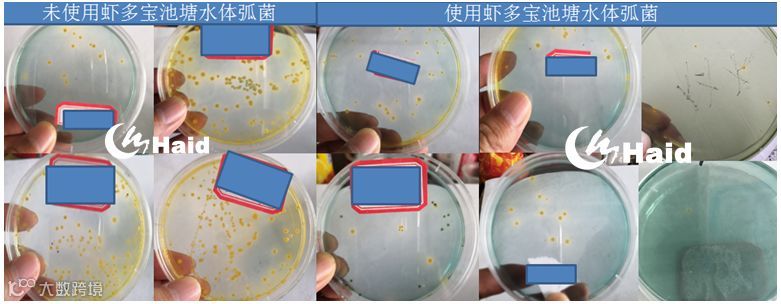

文 | 图 浙江海大 张慧
一、背 景
苗种的问题一直困扰着浙江南美白对虾养殖行业,2017年的苗种问题导致部分养殖户利益受损,养殖行业士气低落。接下去的外塘养殖,天气好,低密度大虾养殖盈利比例提高,大家重拾信心。
反复总结,大棚还是晚点放苗比较好、生物防控鱼类的混养没必要已经成为大多数养殖户的2018年放养规划。正是在去年的背景基础下,对于今年的养殖,部分大棚模式养殖户的规划有了以下改变。
放苗时间:浙江区域大棚放苗最早也推迟到3月初,而大部分是在3月底4月初放苗。
放苗密度:密度方面2018年没有多大改变,以淡化苗5万左右/亩为主流,少部分套养鮰鱼花白鲢,基本都没有放鲫鱼;

2018年萧山绍兴2、3、4三个月放苗数量分布
二、2018年市场养殖情况
天不如人愿,今年的大棚养殖同样不顺利,虽然规避了前期温度低的问题,但是苗种、发病问题直接导致今年大棚养殖行情比之2017年还要问题多。
萧山绍兴大棚养殖户统计160人,发病统计62人,单从发病比例来看就有30%,这里的30%属于亏损。萧山绍兴6个亿的大小棚苗种放养,大棚4个亿,1.2亿发病亏损,这样算也有30%的苗种养殖失败亏损。

2018年萧山绍兴大棚发病类型比例
发病情况分析来看,主要集中在孢子虫苗种问题以及副溶血弧菌引起的偷死病症方面。前者直接导致养殖失败,其它情况在养殖管理合理的情况下还能挽回部分损失。


发病情况展示
从虾价情况分析,5月直至下旬25日左右虾价直线下降,截止月底,已经有上升趋势。主要原因:
① 前20天来看今年养殖节奏比较快,出虾集中,陆续发病直接导致价格一度下降;
② 今年的大棚养殖周期明显缩短,受发病影响,出虾频率高、结束早,目前市场上存塘虾相对减少。

以上是2018年养殖整体情况。总的来说,今年受苗种影响导致亏损近2成以上,其它发病等影响也有2成或平或亏,也有4-5成以上的养殖户盈利。基本能预计今年的大棚养殖盈平亏有5/2/3。
三、海大养殖户养殖效果
盈利还是亏损,除了苗种问题,养殖管理同样不可忽视。下面我们看看市场上盈利比例较大海大客户的养殖情况。30个大棚海大放苗客户基本都已出过头网虾,盈利率评估在95%以上。
苗种:


2018年海兴农苗场在这浙江萧山区域重新选址,具备优越的基础条件。总结原因如下:
① 水源好,育苗期间水质稳定,经检测,隔壁大水库各项指标正常,矿物元素比例合理且没有污染排放,孢子虫等影响对虾养成的病源基本没有;
② 苗场面积够大,足够按照海兴农的淡化设计硬件设施,这样,苗池及水处理池足够,淡化高峰期有足够空间轮作育苗;
③ 海兴农总部结合浙江当地养殖模式,配合当地浙江海大技术服务部门定下了匹配的“快大体系”苗种、严格苗种检测关卡。

客户非常认可海大苗
数据分析海大苗种大棚养殖的成功率相比市场的数据价值化。(统计客户172人,去除没产量塘口数据)

去除直接排塘的,投放不同的苗种在此次数据分析中差异也非常明显,海大苗大棚户明显最高,盈利比例在9成以上,远高于市场平均的2到3成。
饲料:

养殖效果:

沈老板是今年海大放苗相对较早养户之一,也是第一个卖虾的海大苗种养户,当前已经能看到这一个塘口的好效益。亩利润超2万,非常喜人的土塘养殖成绩,而饲料的效果表现也很抢眼,0.72的饵料系数以及前期0.13 g/天的日增重完全体现了虾多富的优质高效!
大部分海大苗种大棚养殖户没有清塘,我们看看其它卖虾效果。

海大虾多富数据价值化体现

去除直接排塘的,使用不同饲料产量对比明显,其中使用虾多富客户亩产810斤,最高,市场平均579斤。以上数据由于没干塘,按照存塘和已售估算,实际数据都会相应提高。
虾多宝:
从放苗的规划到养殖各阶段的管理方案海大技术服务人员都会匹配到养殖户的日常养殖中,并且跟进服务。
今年的海大客户为什么能做到9成以上的盈利,高于市场平均的4成左右?虾多宝是这一款产品功不可没!虾多宝是对虾养殖中抑制弧菌、稳水、促进消化吸收的必备发酵饲料。
上图是同一天采样测弧菌做的对比,0.1毫升水涂板培养。左边4个未使用虾多宝塘口3个弧菌超标,右边6个使用虾多宝的1个超标,抑制弧菌效果对比明显!
虾多宝可以发酵后使用,也可以直接配合饲料投喂使用。今年大家尤其喜欢发酵,因为这样使用既方便又实惠。
① ph值低,且酸味不刺鼻,代表乳酸菌多,效果好;
② 同时成本150元的发酵制作所得发酵液与市场上买的同体积原液的菌量接近甚至多于原液。

虾多宝、泡菌的使用对大棚养殖盈利比影响分析

附:虾多宝使用方法
1、“泡菌”发酵:虾多宝8包+益菌多8桶+红糖50斤+水1600斤,密封发酵2-3天。
池塘泼水补菌:5-7天用一次,一次20斤/亩;
发酵液拌料投喂:配合VC等产品
2、干拌投喂:虾多宝按比例与饲料一起加水拌匀,密封饲料袋内下一餐投喂(前期1:1,中期1:5,后期1:10-20);
3、直接投喂:对虾白便等不良情况时停料控料,虾多宝代替投喂。
请输入标题 bcdef
【江南养虾人】养虾,全心全意
虾苗料变革!这种新型饲料,与天然饵料媲美,比开口料更容易操作
虾苗发白、漂苗、掉苗频发,是什么原因让虾越来越难养?多年实战经验总结,苗期标粗关键点大集合
请输入标题 abcdefg




